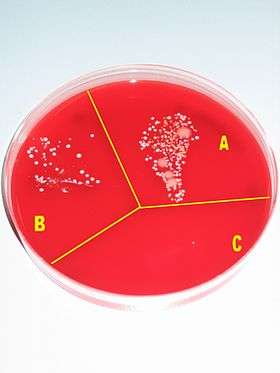

Contemporary reaction to Ignaz Semmelweis
Dr. Ignaz Semmelweis discovered in 1847 that hand-washing with a solution of chlorinated lime reduced the incidence of fatal childbed fever tenfold in maternity institutions. However, the reaction of his contemporaries was not positive; his subsequent mental disintegration led to him being confined to an insane asylum, where he died in 1865.
Semmelweis's critics claimed his findings lacked scientific reasoning. The failure of the nineteenth-century scientific community to recognize Semmelweis's findings, and the nature of the flawed critiques outlined below, helped advance a positivist epistemology, leading to the emergence of evidence-based medicine.
Epistemological relevance

To a modern reader, Semmelweis's experimental evidence—that chlorine washings reduced childbed fever—seem obvious, and it may seem absurd that his claims were rejected on the grounds of purported lack of "scientific reasoning". His unpalatable observational evidence was only accepted when seemingly unrelated work by Louis Pasteur in Paris some two decades later offered a theoretical explanation for Semmelweis's observations: the germ theory of disease.
As such, the Semmelweis story is often used in university courses with epistemology content, e.g. philosophy of science courses - demonstrating the virtues of empiricism or positivism and providing a historical account of which types of knowledge count as scientific (and thus accepted) knowledge, and which do not.
It is an irony that Semmelweis's critics considered themselves positivists. They could not accept his ideas of "minuscule and largely invisible amounts of decaying organic matter" as a cause of every case of childbed fever. To them, "Semmelweis seemed to be reverting to the speculative theories of earlier decades that were so repugnant to his positivist contemporaries".[1]
The positivistic contempt for theoretical deliberations is evident in these two quotations. The first from the highly celebrated anatomist Rudolf Virchow who said, "Explorers of nature recognize no bugbears other than individuals who speculate"[2] , and Johann Lucas Boër said: "If every century could produce one physician as observant (as Hippocrates) rather than so many who are educated in theoretical systems, how much more would have been achieved for humanity and for animal life generally".[3]
(For an example of an earlier dead-end speculative theory that had halted scientific development, see phlogiston).
Absorption of cadaveric material

Semmelweis's key claim was that physicians contaminated their hands with "cadaveric particles" in the morgue while conducting autopsies. He pointed out that ordinary washings with soap did not remove these particles, because the hands could retain a stench for several days in spite of such washings. When physicians later carried out gynaecological examinations, the cadaveric particles were absorbed by the patient, in particular if they came into contact with the freshly exposed uterus, or with genital tract lesions caused by the birth process. Semmelweis was convinced that every case of childbed fever was caused by resorption of cadaveric particles. With this etiology, Semmelweis identified childbed fever as purely an iatrogenic disease—that is, one caused by doctors. (Friedrich Wilhelm Scanzoni von Lichtenfels took personal offense at this, and never forgave Semmelweis for it[4]—Scanzoni remained one of the most ardent critics of Semmelweis.)
A few childbed fever case stories, described below, did not fit well into Semmelweis's theory and led him to expand it, also to comprise other types of decaying organic matter, for instance secretions from an infected knee or from a cancer tumor.
In a case of discharging cancer of the innermost part of the uterus, Semmelweis wrote:
In October 1847, a patient was admitted with discharging medullary carcinoma [cancer of the innermost part] of the uterus. She was assigned the bed at which the rounds were always initiated. After examining this patient, those conducting the examination washed their hands with soap only. The consequence was that of twelve patients then delivering, eleven died. The ichor from the discharging medullary carcinoma was not destroyed by soap and water. … Thus, childbed fever is caused not only by cadaverous particles adhering to hands but also by ichor from living organisms.[5]
And in a case of a discharging carious knee, he wrote:
A new tragic experience persuaded me that air could also carry decaying organic matter. In November of the same year, an individual was admitted with a discharging carious left knee. […] the ichorous exhalations of the carious knee completely saturated the air of her ward. In this way the other patients were exposed and nearly all the patients in that room died. […] The ichorous particles that saturated the air of the maternity ward penetrated the uteruses already lacerated in the birth process. The particles were resorbed, and childbed fever resulted.[5]
Even with the most meticulous chlorine-washings there seemed to be an unavoidable mortality rate of about 1 percent. He therefore suggested that self-infection took place - that internally generated cadaveric particles were responsible, for instance tissue crushed in the birth process and eventually turning gangrenous.
Most of the objections from Semmelweis's critics stemmed from his claim, that every case of childbed fever was caused by resorption of cadaveric particles. Some of Semmelweis's first critics even responded that he had said nothing new - it had long been known that cadaveric contamination could cause childbed fever. But this was only one of many possible causes for childbed fever. The findings from autopsies of deceased women also showed a confusing multitude of various symptoms, which emphasised the belief that puerperal fever was not one disease, but rather many different diseases, which remained unidentified. Semmelweis's critics were also quick to point out that he had virtually no evidence for his self-infection theory.
Rejected as unscientific

The quotes below are so selected to demonstrate the speculative theoretical nature of the objections to Semmelweis's theory. The quotes are from a publication[6] by Carl Edvard Marius Levy, a Danish obstetrician, who attacked Semmelweis's findings on such grounds. The first quote shows the improbable, shabbily researched and poorly argued nature of Semmelweis's claim, that there is only one universal cause for the disease.
...Above all it is to be regretted that neither the observations nor the opinions grounded on them are presented with the clarity and precision that would be desirable in such an important matter of etiology. To presume that corpses can and do infect, without considering whether the infection is derived from puerperae or from other corpses, is as much a consequence of unrecognized a priori assumptions as of the cited facts. A strict examination would absolutely require that different sources of infection be taken into account and provide the basis for a classification of the observations. From a scientific point of view, particularly regarding the question of the contagiousness of puerperal fever, it is important to know whether the presumed cadaveric infection is to be ascribed only to puerperal cadaverous matter or rather to all cadaverous effluvium in general. ..[...]... It would be enlightening, insofar as the discussion concerns only puerperal corpses, to consider whether the contagium is present in the superficial parts, since we are concerned with the products of a disease assumed to be transferable to nearby predisposed persons. On the other hand, if the infective matter can originate from all corpses, one must give up every notion of a specific contagium and look instead for an infection of the blood mass.[7]
... if Dr. Semmelweis had limited his opinion regarding infections from corpses to puerperal corpses, I would have been less disposed to denial than I am. ...[...]... the specific contagium seems to be of little importance to Dr. Semmelweis. Indeed it is so little considered that he does not even discuss the direct transmission of the disease from those who are ill to healthy persons lying nearby. He is concerned only with general infection from corpses without respect to the disease that led to death. In this respect his opinion seems improbable.[7]
Doctors and students did wash hands with soap and water and the hands were visibly clean before examinations. How could contaminants in such infinitesimal amounts possibly cause such damage?
...a rapidly fatal putrid infection, even if the putrid matter is introduced directly into the blood, requires more than homeopathic doses of the poison. And, with due respect for the cleanliness of the Viennese students, it seems improbable that enough infective matter or vapor could be secluded around the fingernails to kill a patient.[8]
Why were simpler and more reliable experiments not considered?
To prove his opinion, Dr. Semmelweis ordered chlorine washings to destroy every trace of cadaverous residue on the fingers. Would not the experiment have been simpler and more reliable if it had been arranged, at least during the experiment, that all anatomical work would be avoided?[9]
Levy suggests that the decrease in deaths could be due to random variation:
In spite of these reservations, one must admit that the results of the experiment appear to support Dr. Semmelweis's opinion, but certainly one must admit no more. Everyone who has had the opportunity to observe the periodic variations in the mortality rate of maternity clinics will agree that his findings lack certain important confirmation. ...[...]... In the absence of more precise statistical information, it is conceivable that the results of the last seven months depend partially on periodic accidental factors …[10]
Semmelweis's critics were also quick to point out that he had virtually no evidence for his self-infection theory. In particular, it seemed unlikely that the two women could have infected other patients without becoming infected themselves:
... the first case [the woman with a carious knee] is clearly inconsistent with the possibility of infection [since presumably she must have infected herself], while the second case [the woman with the cancer in her uterus] remains strikingly unclear. Could ichor from this patient have been more damaging when conveyed in vaginal examinations to other patients than it would have been as a result of similar examinations carried out on this patient herself? In our hospital we have frequently recorded ichorous sores on the feet of delivering patients without having noticed any subsequent infections, either of those patients themselves or of other patients. Dr. Semmelweis places great emphasis on the better health of institutions exclusively for the education of midwives; he should consider that ichorous secretions occur equally in both institutions. Moreover, in an institution as large as the midwife clinic in Vienna, one or another of the patients must always be ill and so provide a source of infection. If the infection occurs as easily as he believes, this would reduce the inequality in mortality rates between the clinics.[11]
In conclusion Professor Levy writes:
These are my impressions of Dr. Semmelweis's experiences; for these reasons I must judge provisionally that his opinions are not clear enough and his findings not exact enough to qualify as scientifically founded.[12]
Impact of Professor Levy's criticism
The Levy paper was first published in 1848, in a Danish journal.[6] A translation was published in Germany by Gustav Adolf Michaelis in 1850.[13] The actual impact on the medical community of the criticism is unclear. Semmelweis only learned of the essay in 1858[4] but evidently finds it significant enough to address it thoroughly in his 1861 publication. The purpose of quoting the Levy paper is that it demonstrates the nature of the criticism, in particular the intricate theoretical reasoning that completely overshadowed Semmelweis' experimental results.
Semmelweis's misconception of childbed fever
Today it is well known that Semmelweis was wrong about the theory of cadaveric contamination. What Semmelweis did not know is that chlorinated lime not only destroys the stench on contaminated hands, but also the bacteria there—the germ theory of disease had yet to be discovered. Many of the epidemics of childbed fever were probably caused by streptococcus infections—either type A, which is commonly found in the throat and nasopharynx of otherwise healthy carriers, or type B, which lives on the skin. Type B is also found in the genitals of about 5–30% of pregnant women.[14] It is therefore necessary for the physician to disinfect their hands before every examination and not, as Semmelweis thought, only after visits to the morgue.
See also
References
Notes
- ↑ Semmelweis 1861:45
- ↑ From his Collected Papers on Scientific Medicine Virchow, Rudolf (1856). Gesammelte Abhandlungen zur wissenschaftlichen Medicin. (Frankfurt am Main: Meidinger and Sohn. p. 737. quoted in Semmelweis (1861):228 (translator Carter's note 75)
- ↑ Boër, Rogers Lucas Johann (1810). Abhandlungen und Versuche zur Begrundung einer neuen, einfachen und naturgemässen Geburtshülfe. vol. 2. Vienna: von Mösk. p. 3. quoted in Semmelweis (1861):228 (translator Carter's note 76)
- 1 2 Hauzman, Erik E (2006). "Semmelweis and his German contemporaries". 40th International Congress on the History of Medicine, ISHM 2006. Budapest, Hungary August 26–30, 2006. Archived from the original (DOC) on May 30, 2008. Retrieved 2008-06-05.
- 1 2 Semmelweis (1861):93
- 1 2 Levy, Karl Edouard Marius (1848). "De nyeste Forsög i Födselsstiftelsen i Wien til Oplysning om Barselfeberens Aetiologie". Hospitals-Meddelelser. 1: 199–211. (Alternative spelling Carl Edvard Marius Levy.) A scan of the 1848 document is available (in Danish) in Wikimedia commons. A plain text version is available in the Danish Wikisource.
- 1 2 Semmelweis (1861):182
- ↑ Semmelweis (1861):182–183
- ↑ Semmelweis (1861):183
- ↑ Semmelweis (1861):184
- ↑ Semmelweis (1861):185
- ↑ Semmelweis (1861):186
- ↑ Levy (1850). "Gebärhäuser und der praktischen Unterricht in der Geburtshülfe". Neue Zeitschrift fur Geburrskunde. 27: 392–449. Semmelweis (1861):137, translator Carter's footnote 18 p 137
- ↑ Carter (2005):104–108
Books
- Semmelweis, Ignaz (1861). Etiology, Concept and Prophylaxis of Childbed Fever. K. Codell Carter (trans.). University of Wisconsin Press, September 15, 1983. ISBN 0-299-09364-6.
- Carter, K. Codell; Barbara R. Carter (February 1, 2005). Childbed fever. A scientific biography of Ignaz Semmelweis. Transaction Publishers. ISBN 978-1-4128-0467-7.